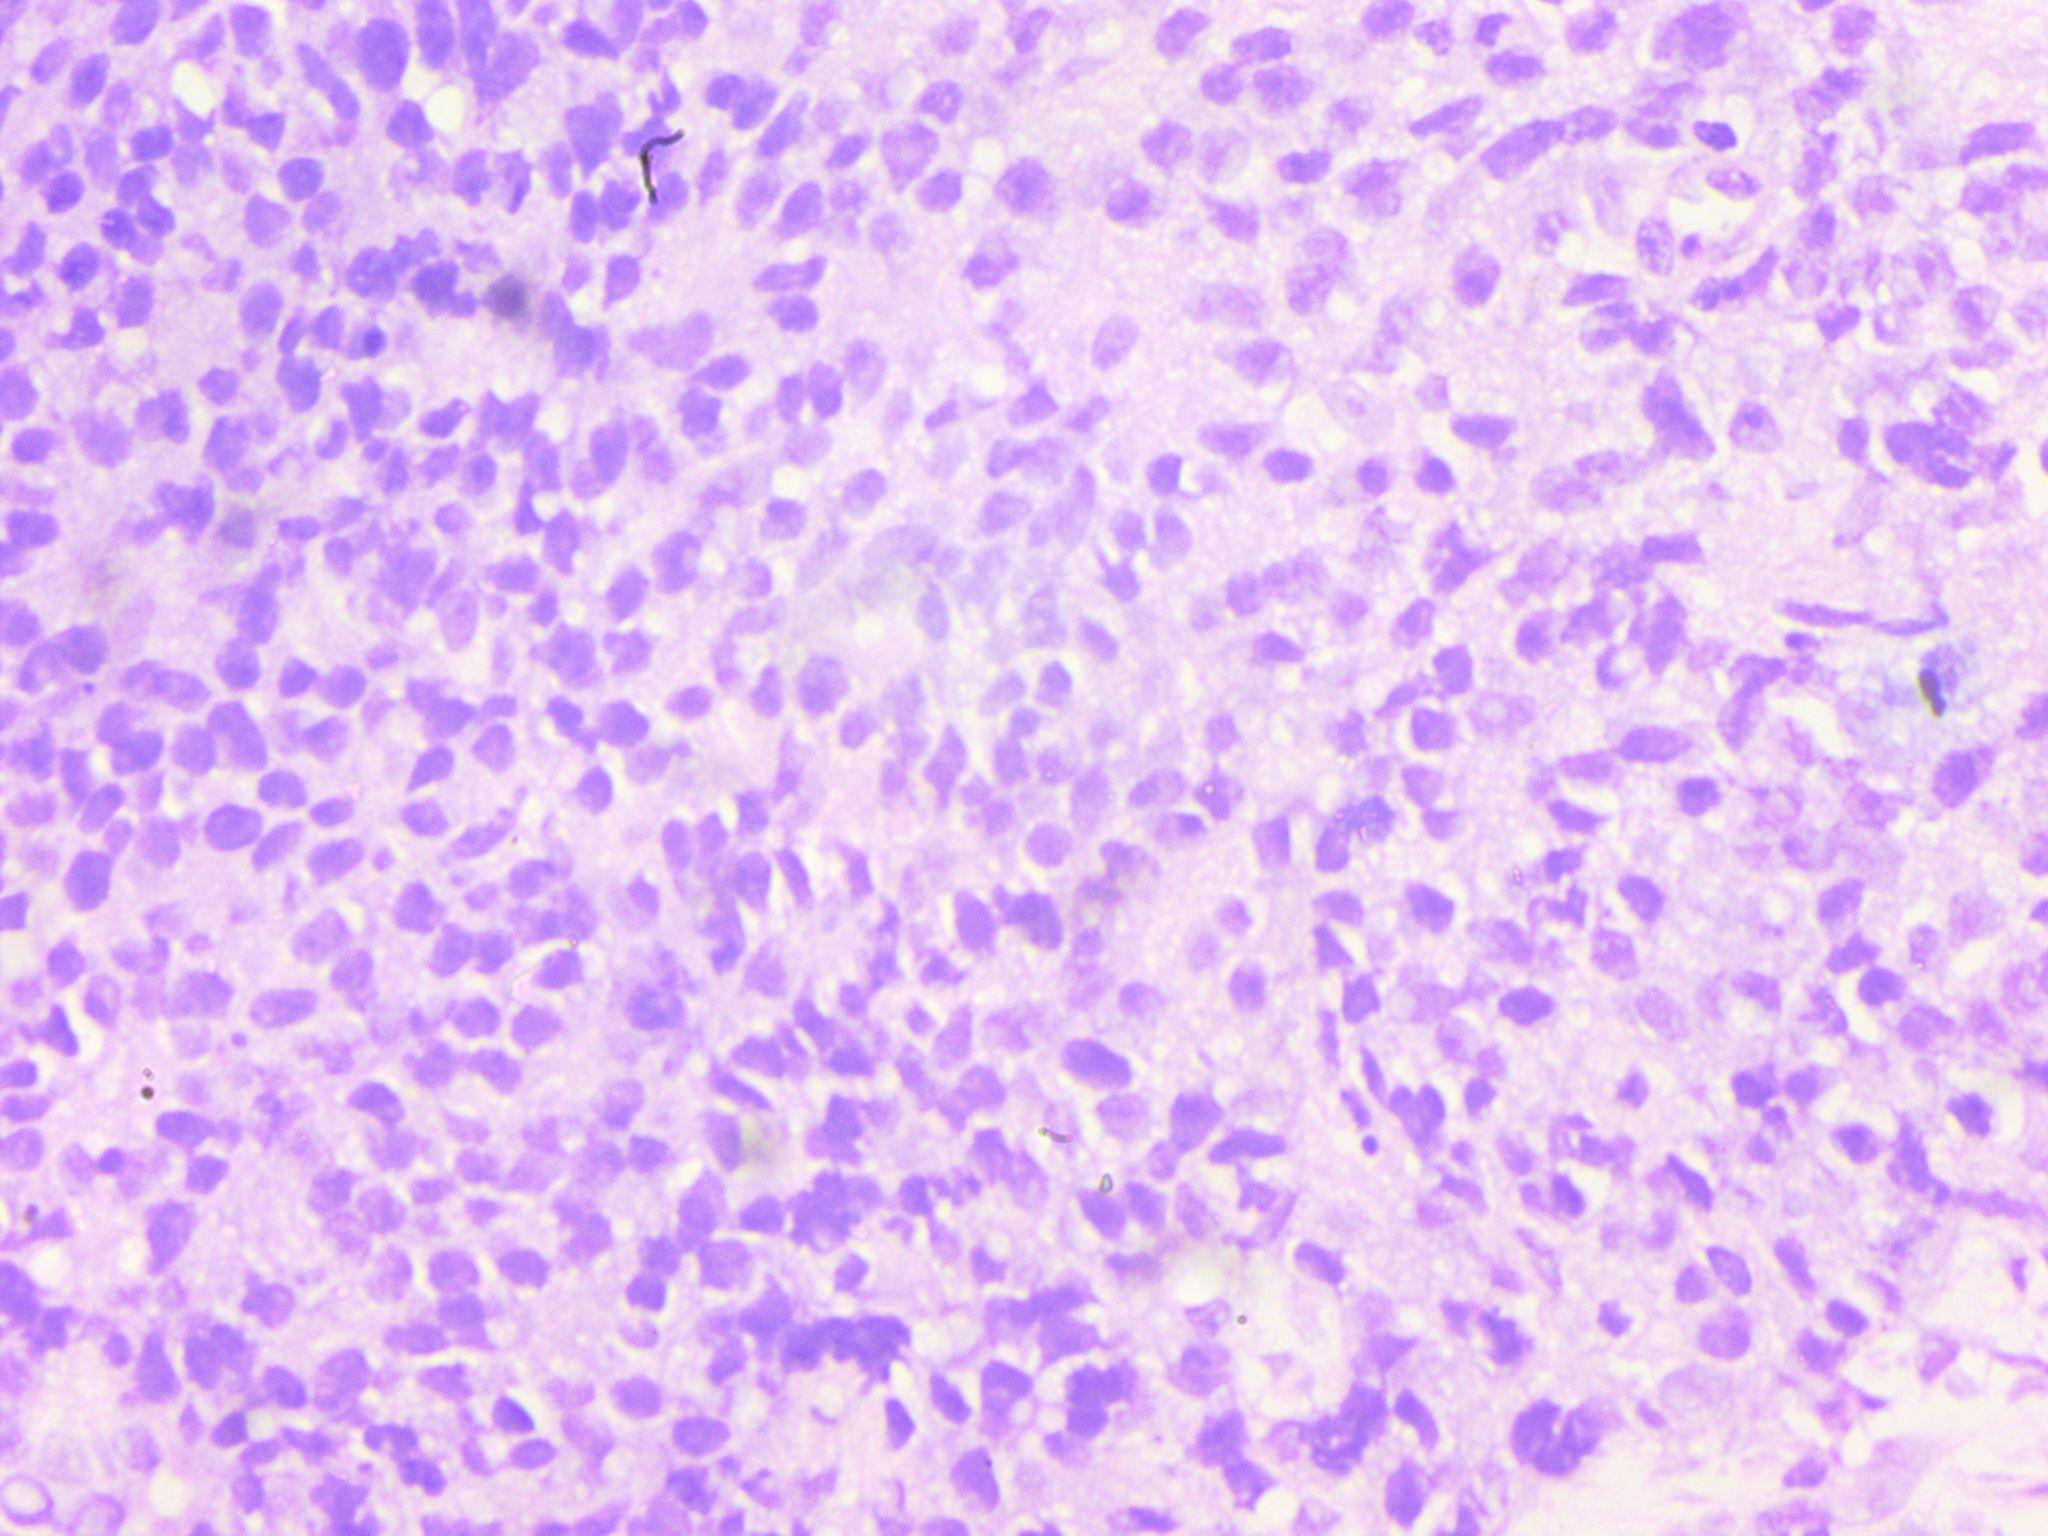

- Visibility 150 Views
- Downloads 50 Downloads
- Permissions
- DOI 10.18231/j.ijpo.2024.019
-
CrossMark
- Citation
Primitive neuroectodermal tumor of the prostate in a 64 years old man: An unusually late presentation
Abstract
Primitive neuroectodermal tumors (PNETs) are uncommon tumors that primarily affect young males. They are rarely seen in the prostate and occurence in an old age group is uncommon. We present a case of a 64-year-old male who presented with complaints of difficulty in passing urine for 1-year duration and on contrast-enhanced computed tomography showed an enlarged mass in the prostate with hypoattenuating areas. Serum prostatic specific antigen was mildly raised. Transurethral resection of prostate was done and histology showed clusters of round cells that expressed CD99. The patient underwent radical surgery for tumor resection. PNETs are tumors of soft tissue origin and generally affect the young age group. This case of PNET in the prostate is unusual for its site and age of presentation. In conclusion, while making a diverse diagnostic evaluation of aggressive prostate cancers, PNET should be taken into account.
Introduction
An extremely uncommon neural crest tumor known as primitive neuroectodermal tumor (PNET) primarily affects children and teenagers. It has a dismal prognosis. PNET and Ewing's sarcoma are assumed to be connected due to their similar clinical, morphological, and immunophenotypic features. PNET is typified histologically by small round cells. Since most PNET cells have the antigen CD99, which the Mic-2 gene encodes, on their exterior surface, it can be used as a helpful diagnostic marker for it. PNET of the prostate was initially documented in 2003.[1] It can originate anywhere in the body and classified into central and peripheral PNETs based on where it is. An embryonal tumor of the central nervous system (CNS) is the term used to describe those originating there. Peripheral PNET (pPNET) is described as PNET that originates from soft tissues, bones, and other parenchymal organs. They frequently show up on imaging as an infiltrative mass with a necrotic area.
Currently classified as a member of the Ewing family of malignancies, a malignant neural crest tumor is called a peripheral primitive neuroectodermal tumor (PNET). PNET and Ewing sarcoma (ES) are specifically regarded to be connected because of their shared translocation of t (11;22) and overlapping cytogenetic characteristics (q24;q12). Ten cases of prostatic PNET have been recorded in the literature so far.[2] According to Coffin and Dehner, only 4.2% of malignant soft tissue sarcomas were caused by peripheral PNET.[3] Here, we describe a case of PNET in the prostate in which dysuria was one of the earliest symptoms.
Case Report
A 64-year-old man reported having dysuria for one year without any clear cause. He also complained of hematuria for 6 months. In addition, the patient reports weight loss, lower abdomen pain, and pelvic discomfort. There was no prior record of any significant illness or malignancy. The patient had no notable medical history or prior urologic history.
Upon physical examination, there was discomfort in the area of the pubic symphysis and a moderately distended abdomen. Upon digital rectal examination, the prostate had a solid, palpable mass that had restricted mobility. Prostate-specific antigen (PSA) in the serum was 20.58 ng/mL. Contrast-enhanced computed tomography shows an enlarged prostate measuring 4.3x3.7x4.5 cm and shows heterogeneous hypoattenuating areas in the region of the left mid gland and base measuring 2.1 x 3.3 cm. Findings suggested prostatic abscess or neoplastic lesion.
A transurethral biopsy of the mass was performed. Histopathological analysis revealed clusters of small round blue cells infiltrating the prostatic tissue. Immunohistochemistry study revealed a high degree of CD99 positivity and diagnosis of prostatic PNET was made.

Discussion
PNET is an aggressive malignancy that is incredibly rare and has a bad prognosis. Less than 0.1% of adult primary prostate cancer cases are primitive neuroectodermal tumors, which are most common in young men between the ages of 35 and 60.[4] There are currently just 17 prostatic PNET instances that have been documented; the first PNET of the prostate was reported in 2003 by Colecchia et al.[1] The majority of the patients in the cases that were published were young people. The oldest case we have described so far is 64 years old. The diagnosis of prostate PNET is quite difficult. PNETs are tumors that predominantly affect bone and soft tissue. Its occurrence in the prostate is rare. The patients frequently give the same complaints as those who have benign prostatic hyperplasia.
Prostatic PNET patients may exhibit hematuria, dysuria, constipation, pelvic pain, and hematochezia. A review of the literature revealed that approximately 40% of prostate cancer patients with PNET have remote metastases. Since the lung is the most typical location for distant metastases, at the time of presentation, every patient with metastatic cancer had at least one pulmonary metastasis. Our patient did not have any metastasis. Even though PSA is a necessary serum marker with a rate of positive detection of 82% for the diagnosis of prostate cancer,[5] our patient's PSA level was mildly increased to 20.58 ng/ml. In malignancy, the PSA level generally increases to many folds because the PSA secretion from affected glands in malignancy. In PNET the stromal component of the prostate is affected by tumor cells. Imaging studies helps in diagnosis, clarify internal structure, and evaluate distant metastases and local invasion. Prostate PNET is represented by a multilobulated mass with heterogeneous enhancement on CT and MRI scans and as an aggressive soft tissue mass that is poorly defined and exhibits hemorrhage, necrosis, and cystic degeneration.[6] When evaluating distant metastases, CT imaging is more helpful. Distant metastases to the lung, bone, and intracranial meninges have been described in patients with prostate cancer treated with PNET.[7]
Histopathological characteristics are crucial in making the diagnosis of a prostatic PNET. PNET appears as a mass of small, round undifferentiated cells cluster densely packed in a lobulated, nest-like, or flaky pattern under a light microscope. Over 90% of PNETs have the EWS-FLI1 fusion gene positive and exhibit a translocation between chromosomes 11 and 22's long arms. PNET's characteristic round cells react to antiCD99 antibodies (Mic-2).[8] A large number of cases follow the diagnosis scheme developed by Schmidt et al, It involves the existence of Homer-Wright rosettes and/or the expression of two or more neural markers.[9] In our case CD99 IHC marker was positive in tumor cells. Radiotherapy, chemotherapy, and surgery combined can be a successful treatment plan for PNET of the prostate. It is common practice to recommend the chemotherapeutic drugs vincristine, doxorubicin, cyclophosphamide, etoposide, and ifosfamide.[8] In 177 patients with localized Ewing's sarcoma, Dunst found that radiotherapy was equally effective in terms of overall survival as surgery or a combination of surgery and radiotherapy. For localized PNET of the prostate, chemotherapy is a potentially useful treatment option, albeit a standard protocol has not yet been established.[10]
Conclusion
We provide a rare and unusual instance of prostate-related PNET. Since it affects predominantly soft tissue and bone, its occurrence in the prostate is rare. In addition, the young age group is generally affected, and presentation in the old age group like in our case is very unusual. Since it is frequently disregarded for its existence, a biopsy using IHC is necessary for a precise diagnosis.
Source of Funding
None.
Conflict of Interest
None.
References
- Colecchia M, Dagrada G, Poliani PL, Messina A, Pilotti S. Primary primitive peripheral neuroectodermal tumor of the prostate. Immunophenotypic and molecular study of a case. Arch Pathol Lab Med. 2003;127(4):190-3. [Google Scholar]
- Liao C, Wu X, Wang X, Li H. Primitive neuroectodermal tumor of the prostate: case report from China. J Cancer Res Ther. 2015;11(3). [Google Scholar]
- Coffin C, Dehner L. Peripheral neurogenic tumors of the soft tissues in children and adolescents: a clinicopathologic study of 139 cases. Pediatr Pathol. 1989;9(4):387-407. [Google Scholar]
- Paulussen M, Fröhlich B, Jürgens H. Ewing tumour: Incidence, prognosis and treatment options. Paediatr Drugs. 2001;3(12):899-913. [Google Scholar]
- Catalona W, Richie J, Ahmann F, Hudson M, Scardino P, Flanigan R. Comparison of Digital Rectal Examination and Serum Prostate Specific Antigen in the Early Detection of Prostate Cancer: Results of a Multicenter Clinical Trial of 6,630 Men. J Urol. 2017;197:200-7. [Google Scholar]
- Valeshabad A, Choi P, Dababo N, Shamim E, Alsadi A, Xie K. Metastatic Primitive Neuroectodermal Tumor of the Prostate: A Case Report and Review of the Literature. Clin Genitourin Cancer. 2018;16(2):343-7. [Google Scholar]
- Funahashi Y, Yoshino Y, Hattori R. Ewing’s sarcoma/primitive neuroectodermal tumor of the prostate. Int J Urol. 2009;16. [Google Scholar]
- Bernstein M, Kovar H, Paulussen M, Randall R, Schuck A, Teot L. Ewing's sarcoma family of tumors: current management. Oncologist. 2006;11(5):503-19. [Google Scholar]
- Schmidt D, Herrmann C, Jürgens H, Harms D. Malignant peripheral neuroectodermal tumor and its necessary distinction from Ewing's sarcoma. A report from the Kiel Pediatric Tumor Registry. Cancer. 1991;68(10):2251-9. [Google Scholar]
- Dunst J, Jürgens H, Sauer R, Pape H, Paulussen M, Winkelmann W. Radiation therapy in Ewing’s sarcoma: An update of the CESS 86 trial. Int J Radiat Oncol Biol Phys. 1995;32(4):919-30. [Google Scholar]
How to Cite This Article
Vancouver
Sharma A, Singhai A, Mondal D. Primitive neuroectodermal tumor of the prostate in a 64 years old man: An unusually late presentation [Internet]. Indian J Pathol Oncol. 2024 [cited 2025 Oct 26];11(1):81-83. Available from: https://doi.org/10.18231/j.ijpo.2024.019
APA
Sharma, A., Singhai, A., Mondal, D. (2024). Primitive neuroectodermal tumor of the prostate in a 64 years old man: An unusually late presentation. Indian J Pathol Oncol, 11(1), 81-83. https://doi.org/10.18231/j.ijpo.2024.019
MLA
Sharma, Akanksha, Singhai, Atin, Mondal, Diparati. "Primitive neuroectodermal tumor of the prostate in a 64 years old man: An unusually late presentation." Indian J Pathol Oncol, vol. 11, no. 1, 2024, pp. 81-83. https://doi.org/10.18231/j.ijpo.2024.019
Chicago
Sharma, A., Singhai, A., Mondal, D.. "Primitive neuroectodermal tumor of the prostate in a 64 years old man: An unusually late presentation." Indian J Pathol Oncol 11, no. 1 (2024): 81-83. https://doi.org/10.18231/j.ijpo.2024.019
